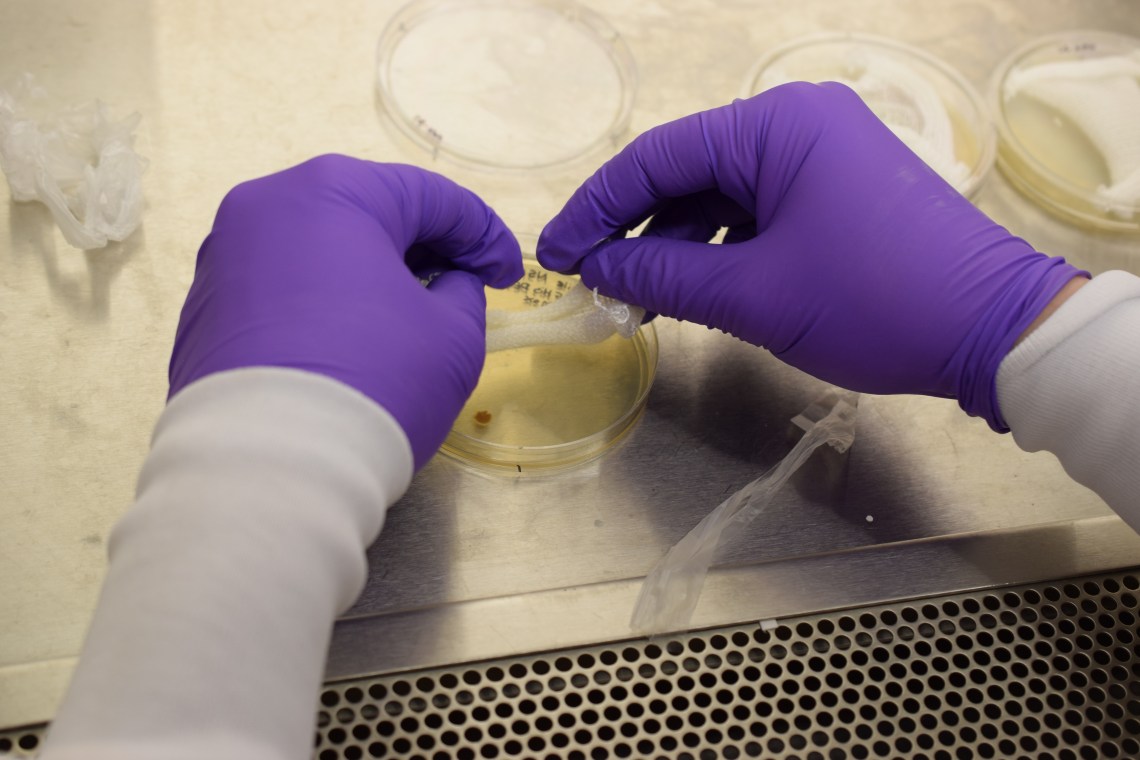

Little Devices Lab, MIT + Self-Assembly Lab, MIT.
This project investigates how wearable textile interfaces can act as extensions of our body and mind to advance awareness and seamless communication with ourselves and the world around us. By embedding medication and health indicators into fibers, textiles become wearable body displays sensing, displaying and releasing information via controlled change in color, texture and shape for new ways of self-discovery, wellbeing and learning. Such interfaces silently communicate and actively engage with the wearer to reveal information about ourselves. Acting as an on body bio-sensor and actuator, these materials interface with the compartments in the body and reflect inner metabolic processes.
Self-Assembly Lab, MIT: Sophie Richter, Lavender Tessmer
Little Devices Lab, MIT: Jonah Butler

Textile-Based Drug-Release Systems
By embedding medication into fibers, textile wearables become drug release systems interfacing with and diffusing medication directly into the skin. First experiments included embedding antibiotics into knitted textiles which were successfully tested in E.Coli colonies, releasing the medication to kill the bacterias. Other substances like Vitamins, blood inhibitors, etc. could be embedded for treatment, healing and nourishment.